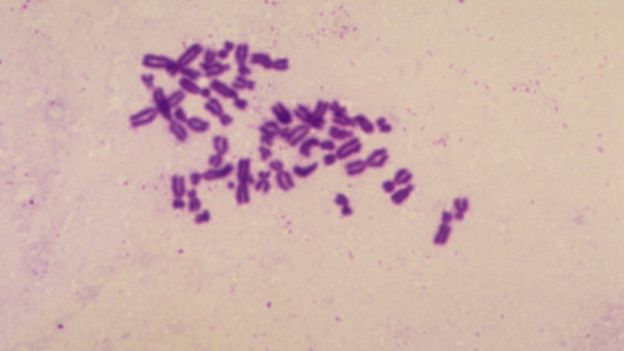

Durante 5 años, el esposo de Claire recibió tratamiento para dos tipos de cáncer.
BBC NEWS MUNDO
“Casi aborto por culpa de una prueba médica que resultó ser poco fiable”
Claire Bell ya puede contarlo con calma, pero tuvo que pasar semanas de angustia y otras tantas de investigación antes de lograrlo.

Claire Bell compartió con BBC su experiencia indagando sobre las pruebas prenatales. (Foto Prensa Libre: BBC)
Cuando finalmente terminó, la pareja decidió intentar tener un bebé a través de fecundación in vitro (FIV), utilizando un esperma que su esposo había congelado y almacenado antes de recibir quimioterapia.
En el primer intento, a la edad de 41 años, quedó embarazada y se sintió increíblemente afortunada.
“Fue un embarazo milagroso”, le dijo Claire a la periodista de la BBC Charlotte Hayward. “El primero de nuestros embriones había funcionado”, contó.
La pareja decidió que quería saber si existía la posibilidad de que el bebé tuviera el síndrome de Down y pagó de forma privada un análisis de sangre conocido como NIPT en inglés, un examen prenatal no invasivo.
La prueba analiza el ADN de pequeñas partículas de la placenta que circulan en la sangre de la madre.
“Mi esposo y yo éramos conscientes de que no podíamos cuidar un bebé con síndrome de Down”, dice Claire, sudafricana y periodista de investigación, que en ese momento vivía en Escocia.
“Después de lidiar con cinco años de tratamiento contra el cáncer, sentimos que no teníamos la fuerza emocional” para afrontar un escenario como ese.

La clínica le dijo a Claire que recibiría un correo electrónico si todo estaba bien, pero que llamarían si había algo de lo que hablar.
Apenas una semana después, mientras Claire y su esposo estaban de vacaciones en Francia, sonó el teléfono. Claire estaba en la ducha en ese momento, y se apresuró a responder la llamada.
Malas noticias
“Corrí hacia el teléfono… y mientras estaba allí, temblando con una toalla, el médico me dijo que había posibilidades de que mi bebé tuviera el síndrome de Turner“.
El síndrome de Turner es una enfermedad cromosómica que solo afecta a las niñas y cuyos síntomas incluyen la baja estatura y tener problemas de fertilidad.
Pero la información que Claire recibió de la clínica pintó un panorama muy sombrío de la vida de las personas con síndrome de Turner.
“Recuerdo que pensé que esto es ciencia, que era un hecho. No podía dejar de llorar, no podía caminar más de 200 metros. Me sentía desesperada”.
Se le ocurrió que interrumpir el embarazo sería lo más amable que podía hacer por su hija.
Pero más tarde, ese mismo día, Claire habló con una amiga que la animó a averiguar más sobre la prueba. Y cuando lo hizo, descubrió que su resultado podía no ser tan trágico como parecía.
El test NIPT está disponible para cualquier mujer o pareja que quiera pagar su coste, de hasta US$650.
Se utiliza principalmente para detectar el síndrome de Down y otras dos anomalías cromosómicas, el síndrome de Edwards y el síndrome de Patau.
Los profesionales médicos están de acuerdo en que, cuando se usa correctamente, es bastante fiable como prueba para estas condiciones.
Pero cuando se realizan pruebas para detectar otras condiciones más raras, la eficacia del test no está rigurosamente demostrada en entornos clínicos.
Claire Bell
Mientras estaba allí, temblando con una toalla, el médico me dijo que había posibilidades de que mi bebé tuviera el síndrome de Turner
Un artículo en la revista médica Ultrasonidos en Obstetricia y Ginecologíaargumenta que cuando se usa para detectar estas afecciones, incluido el síndrome de Turner (cuando una niña tiene solo una copia del cromosoma X) o el síndrome de Klinefelter (cuando un niño tiene dos copias del cromosoma X y un cromosoma Y) tiene “una alta tasa de fracaso“, una baja tasa de detección y una cifra alta de falsos positivos.
Uno de los autores de ese informe, Kypros Nicolaides, profesor de medicina fetal en el King’s College Hospital, dice que las mujeres que han recibido un NIPT perturbador en una clínica privada a menudo recurren al sistema público de salud en busca de ayuda.
Pruebas incorrectas
“La prueba NIPT puede analizar la presencia de varias enfermedades, pero no tenemos información sobre qué tan efectivo y valioso es el método de detección”, afirma Nicolaides.
“Hay muchas mujeres que se hacen estas pruebas, acuden a nuestra consulta extremadamente preocupadas y acaban sometiéndose al test invasivo, que es lo que querían evitar, y el resultado es que la prueba NIPT es incorrecta“, añade.

La prueba invasiva a la que Nicolaides se refiere es o bien una biopsia de placenta o bien una amniocentesis, es decir, un análisis del líquido del saco amniótico. Ambos tests tienen un pequeño riesgo de aborto involuntario.
Claire Bell no pasó por este tipo de prueba invasiva, porque mientras más leía sobre la prueba NIPT como método de detección del síndrome de Turner, más escéptica se volvía.
Leyó en internet sobre bebés de mujeres a los que se les diagnosticó el síndrome de Turner de forma errónea.
Y leyó de una embarazada cuyo médico le había dicho que la prueba era tan poco confiable que era más o menos lo mismo que lanzar una moneda al aire.
Luego leyó que el valor predictivo positivo (VPP) de la prueba para el síndrome de Turner, la proporción de resultados positivos y negativos que finalmente resultan ser realmente positivos y negativos, es de apenas 40% para una mujer de 41 años.
Claire Bell
Recuerdo que pensé que esto es ciencia, que era un hecho. No podía dejar de llorar, no podía caminar más de 200 metros. Me sentía desesperada.
Llamó al médico que le había dicho sobre su resultado por teléfono y le preguntó si esto era correcto.
“Sí, pero no lo sabemos“, le respondió.
Aún sin saber qué era lo mejor, Claire llamó a su tía en busca de perspectiva.
Le describió algunos de los síntomas que las niñas con síndrome de Turner pueden desarrollar, incluido el hecho de que no tienen discapacidades intelectuales, pero pueden tener problemas con el razonamiento espacial y las matemáticas.
“No puedes abortar un bebé porque podría ser baja, tener pecho plano o problemas con las matemáticas”, le dijo su tía. “Y además, somos de Yorkshire, somos fuertes y lo sabes. No te dejes llenar de dudas“.
Seguimientos clínicos
Entonces Claire decidió tratar el tema como una de sus investigaciones periodísticas y llamó al laboratorio que analizó su sangre.
Le preguntó con qué frecuencia hacían seguimientos para saber si un bebé diagnosticado con altas probabilidades de nacer con síndrome de Turner acababan teniéndolo.
La respuesta fue que ellos nunca lo hacían.

La científica del laboratorio con la que habló recalcó que Claire parecía no haber recibido el asesoramiento que se recomienda antes de realizarse la prueba, por lo que esta decidió llamar a su clínica para preguntar al respecto.
Su médico respondió que en Estados Unidos le habrían dado cuatro horas de asesoramiento antes de la prueba, pero que en Reino Unido no había suficientes expertos en genética que pudieran tener esa charla con ella.
La clínica a la que Claire asistió dice que los pacientes reciben asesoramiento y consejo sobre las estadísticas de los falsos positivos.
Añade que “informa a los pacientes de todos los resultados de las pruebas de manera segura, sensible y les da todo el apoyo que necesitan” y que, si bien no proporciona información genética específica, respalda a los pacientes con un consultor obstétrico en postratamientos.
En su declaración, la clínica también dice que sigue “operando de manera ética, profesional y en el mejor interés del paciente”.
“Continuaremos trabajando según los estándares profesionales, a la vez que otorgaremos a los hombres y mujeres el derecho a elegir“, añade.
Uso complementario
Claire continuó investigando y leyendo artículos en revistas médicas.
Se sorprendió al descubrir que la misma compañía que inventó la prueba sugirió que podría no ser adecuada para enfermedades como el síndrome de Turner.
En su lugar, dijo, era mejor usarla como complemento, en los casos en que exista un historial familiar de una anomalía cromosómica similar o cuando una ecografía había dado motivos para suponer que tal anomalía podría estar presente.

“La idea de que podría haber interrumpido este embarazo, es decir…”, dice, deteniéndose para encontrar las palabras adecuadas. “Es tan importante que las mujeres sepan que esta prueba tiene bastantes falsos positivos“.
En junio de 2018 nació la hija de Claire, Fintry, y no parece tener síntomas del síndrome de Turner. Es pequeña, pero hay personas bajas en la familia.
Claire hará un análisis de sangre a Fintry cuando cumpla un año para averiguar si tiene la enfermedad. Pero no antes, aclara.
“Quería que ella fuera una persona completa en mi mente, para que la conozca totalmente antes de asociar con ella una enfermedad”, explica.
“Está sana, es hermosa y siempre sonríe”.
Robert Cuffe, responsable de estadísticas en BBC News, agrega: “Lo mejor es preguntarle al médico antes de tomar decisiones importantes y, si está tentado de preguntarle al Dr. Google, busque cuán común es la enfermedad antes de sacar cualquier conclusión”.



